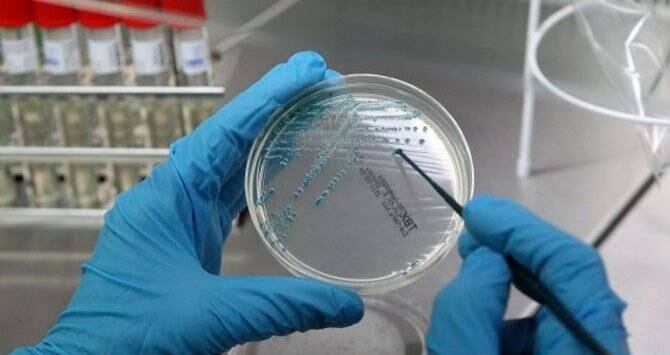

Este jueves fue publicado en el diario oficial la recién creada Ley del Banco de Datos Genéticos para Uso Forense, la cual entrará en vigencia dentro de ocho días.
Se trata del decreto número 22-2017, el cual establece la creación del referido banco para recopilar la información genética y de esa forma facilitar el esclarecimiento de los hechos que sean objeto de una investigación criminal.
De acuerdo con la publicación, este registro será administrado por el Instituto Nacional de Ciencias Forenses (Inacif), el cual “pondrá a disposición inmediata del Ministerio Público toda la información, la que únicamente podrá usarse para la investigación criminal y los procesos respectivos”.
El decreto destaca que es necesario dotar de herramientas y modernizar la investigación criminal, a través de la identificación por medio del análisis genético forense, y de esa manera tener mayor certeza acerca de la responsabilidad de los individuos en hechos criminales.
Lee también: Oficialismo no logra apoyo para elegir directiva y bloquea ley
De igual forma, menciona que los delitos sexuales contenidos en la Ley contra la Violencia Sexual, Explotación y Trata de Personas, incluyen la sanción para responsables de esos delitos; sin embargo, “no aborda integralmente la reincidencia de estas conductas delictivas”.
Registro de agresores sexuales
El artículo 6 del decreto hace referencia a que el Ministerio Público llevará un Registro Nacional de Agresores Sexuales, sobre las personas que hubieren sido condenadas por delitos contra la libertad e indemnidad sexual.
Este incluirá información cómo nombres y apellidos, así como pseudónimos o sobrenombres de la persona; su fotografía actualizada, su fecha y lugar de nacimiento, nacionalidad, número de Documento Personal de Identificación o de pasaporte, si es extranjera.
También, su dirección de trabajo y el nombre de la empresa donde trabaja, su puesto y lugar de trabajo.
El registro estará vigente a partir del 1 de enero de 2018.
Lee también: “Quien lo sufre no sabe que es víctima”, dice fiscal sobre pornografía infantil
Información de personas detenidas
El decreto 22-2017 menciona además que el sistema de almacenamiento y sistematización de la información de las personas que sean aprehendidas por cualquier delito iniciará a funcionar a partir del 1 de enero de 2019.
Este se menciona en el artículo 3, denominado “banco genético”, que además de datos relacionados con los detenidos, incluirá muestras biológicas obtenidas en el curso de una investigación criminal.
“El objetivo de esto es alimentar de oficio, por cualquiera de las dos vías, el Banco de Datos Genéticos”, menciona la publicación.
No solo quienes estén involucrados en la comisión de delitos estarán en el registro, pues existe la “donación voluntaria”.
“Cualquier persona, o menor con autorización de sus padres que tenga la guardia y custodia, podrá acudir al Inacif a dar su muestra voluntariamente de ADN para que se archive en el Banco Genético”, dice la ley.